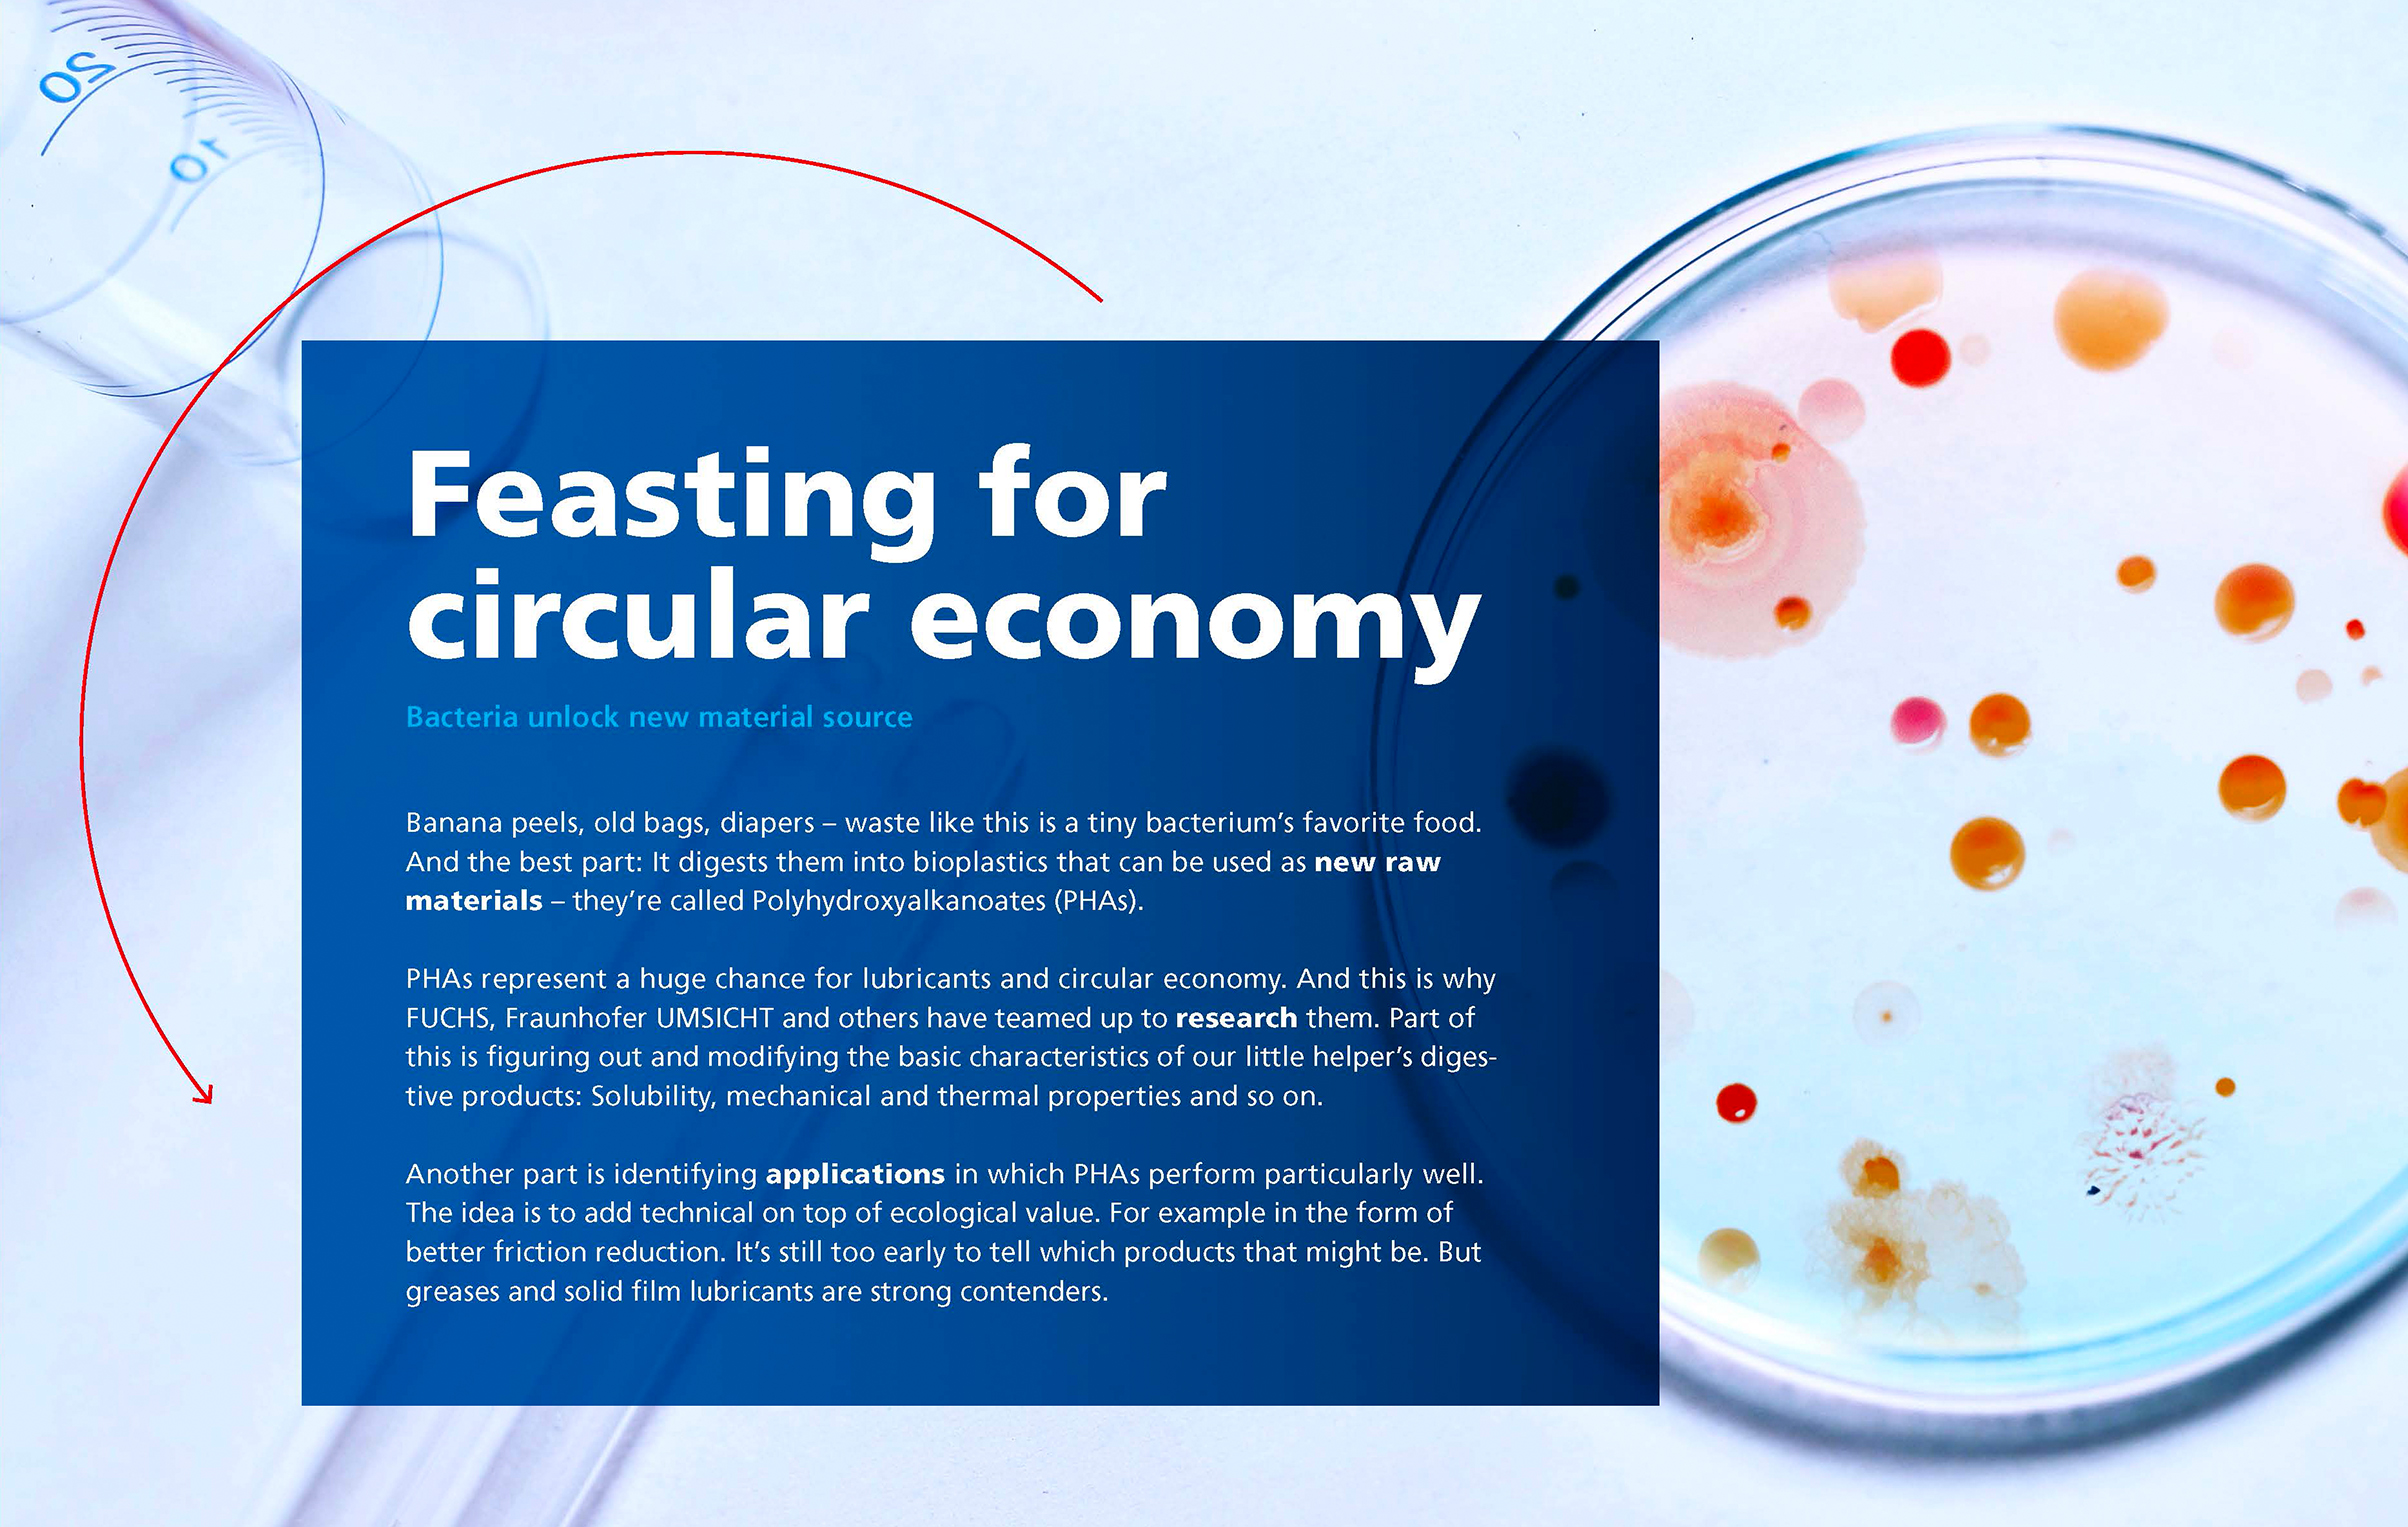

Nach dem Motto „Komplexes leicht verständlich“ entwickelten wir Themenreports für den Nachhaltigkeitsbericht von FUCHS. Der Produzent von Schmierstofflösungen will bis 2040 klimaneutral sein. Ein ehrgeiziges Projekt und ein langer Weg zum Ziel. Die Inhalte dabei sind sperrig und ohne Fachwissen nicht für jeden verständlich. Ein Projekt wie gemacht für zet die agentur.
Nachhaltigkeit ist ein Thema, das jeden angeht. Deshalb machen wir die Strategie von FUCHS einer breiten Öffentlichkeit zugänglich. Die Themenbeiträge bringen ausgewählte Projekte in einer kurzen Text-Bild-Story auf den Punkt – anschaulich und allgemein verständlich. Sie schaffen Vertrauen in die Aufrichtigkeit des Anliegens und die Umsetzung der Nachhaltigkeitsziele.
Die komplexen Texte haben wir in Allgemeinverständlichkeit übersetzt. Lange Satzungeheuer wurden gekürzt, entlegene Anglizismen und Fachausdrücke verbannt. Eine visuelle Inszenierung und erklärende Illustrationen sorgen zusätzlich für mehr Anschaulichkeit und Lesefreude. Als Ganzes geben die kleinen Stories ein spannendes Bild von der engagierten Entschlossenheit, mit der ein Unternehmen das Thema Nachhaltigkeit vorantreibt.
Klare Bekenntnis zu einer Strategie in zwei Schritten zur Erreichung der Klimaneutralität.

Forschung nach neuen Rohstoffen, die biobasiert und biologisch abbaubar sind.
Entwicklung von Produkten, die Kunden helfen, nachhaltiger zu werden, indem sie Energie einsparen und die Umwelt entlasten.

Bewertung und Prüfung von dritter Seite hinsichtlich Ernsthaftigkeit und Glaubwürdigkeit aller Maßnahmen.

Erste konkrete Schritte, um Rohmaterialien nach und nach durch erneuerbare, biobasierte oder recycelte zu ersetzen.

Für einheitliche Standards im Verbund mit europäischen Partnern.

1931 als Familienunternehmen in Mannheim gegründet, ist FUCHS heute der weltweit größte unabhängige Anbieter von innovativen Schmierstofflösungen für nahezu alle Industrien und Anwendungsbereiche. Dabei verfolgen die 6.000 Mitarbeitenden in über 50 Ländern bis heute dasselbe Ziel: die Welt nachhaltig und effizient in Bewegung halten. Bedingungslos zuverlässig. Mit Schmierstoffen für alles, was antreibt. Oder angetrieben werden soll.
Wir freuen uns schon darauf, deine Geschichte zu erzählen.